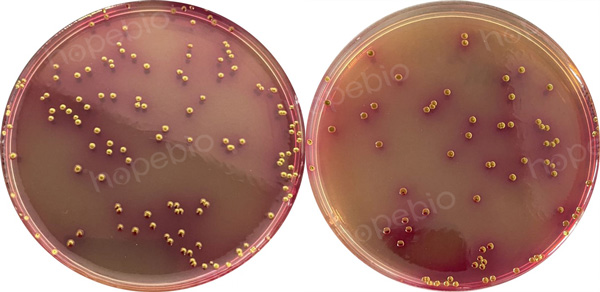

海博微信公众号
海博微信公众号
 海博天猫旗舰店
海博天猫旗舰店


 海博微信公众号
海博微信公众号
 海博天猫旗舰店
海博天猫旗舰店




引言
微生物监测是评估近岸河流水环境质量的重要环节,污水中常含有一定数量的病原微生物,是引发水传播疾病的重要来源。其中较为常见且具有重要影响的包括:沙门氏菌属、志贺氏菌属、粪链球菌、肠道病原性大肠埃希氏菌以及肠道病毒等。前文已简述沙门氏菌属、粪链球菌的测定方法,本文将继续以《水和废水监测分析方法(第四版)》为参考依据,系统阐述总大肠菌群的测定方法与流程,旨在为实际监测工作提供参考。
对于其他近岸河流水微生物检测的相关内容可参考《近岸河流水域微生物检测-沙门氏菌属的测定》、《近岸河流水域微生物检测-粪链球菌测定多管发酵法》等文章。
一、大肠菌群
总大肠菌群是指那些能在37℃ 48h之内发酵乳糖产酸产气的、需氧及兼性厌氧的革兰氏阴性的无芽孢杆菌。上要包括有埃希氏菌属、柠檬酸杆菌属、肠杆菌属、克雷伯氏菌属等菌属的细菌。
总大肠菌群的检验方法中,多管发酵法可适用于各种水样(包括底泥),但操作较繁,需要时间较长;滤膜法主要适用于杂质较少的水样,操作简单快速。如果是使用滤膜法,则总大肠菌群可重新定义为:所有能在含乳糖的远藤氏培养基上,于37℃ 24h之内生长出带有金属光泽暗色菌落的、需氧的和兼性厌氧的革兰氏阴性无芽孢杆菌。
粪便中存在有大量的大肠菌群(coliform group)细菌,在水体中存活的时间和对氯的抵抗力等与肠道致病菌,如沙门氏菌、志贺氏菌等相似,因此将总人肠菌群作为水体受粪便污染的指示菌是合适的。
二、大肠菌群的测定
大肠菌群的测定主要为多管发酵法和滤膜法。本篇主要介绍第一种方法多管发酵法。
多管发酵法是根据人肠菌群细菌能发酵乳糖、产酸产气以及具备革兰氏染色阴性、无芽孢、呈杆状等有关特性,通过三个步骤进行检验,以求得水样中的总大肠菌群数。
多管发酵法是以最可能数(most probable number)简称MPN来表示试验结果的。实际上它是根据统计学理论,估计水体中的大肠杆菌密度和卫生质量的一种方法。如果从理论上考虑,并且进行大量的重复检定,可以发现这种估计方法会有大于实际数字的倾向。不过只要每一稀释度试管重复数目增加,这种差异便会减少,对于细菌含量的估计值,大部分取决于那些既显示阳性又显示阴性的稀释度。因此在实验设计上,水样检验所要求重复的数目,要根据所要求数据的准确度而定。
1.培养基
(1)乳糖蛋白胨培养液HB0119乳糖蛋白胨培养液
(2)品红亚硫酸钠培养基HB0118品红亚硫酸钠琼脂
(3)伊红美蓝琼脂HB0107伊红美蓝琼脂(EMB)
2.步骤
(1)生活饮用水
① 初发酵试验:在两个装有已灭菌的50 mL三倍浓缩乳糖蛋白胨培养液的大试管或烧瓶中(内有倒管),以无菌操作各加入已充分混匀的水样100mL;在10支装有已灭菌的5mL一倍浓缩乳糖蛋白胨培养液的试管中(内有倒管),以无菌操作加入充分混匀的水样10mL,混匀后置于37℃恒温箱培养24h。
② 平板分离:经初发酵试验培养24 h后,发酵试管颜色变黄为产酸,小倒管内有气泡为产气、将只产酸及产气产酸发酵管,如图1,分别用接种环划线接种于品红亚硫酸钠培养基或伊红美蓝培养基上,置37℃恒温箱内培养18h~24h,挑选符合下列特征的菌落,取菌落的一小部分进行涂片、革兰染色、镜检。

图1只产酸及产酸产气的发酵管特征(左2为只产酸,右2为产酸产气)
品红亚硫酸钠培养基上的菌落:紫红色,具有金属光泽的菌落;深红色,不带或略带金属光泽的菌落;淡红色,中心色较深的菌落。如图2。
图2 大肠菌群在品红亚硫酸钠培养基上的特征
伊红美蓝培养基上的菌落:深紫黑色,具有金属光泽的菌落;紫黑色,不带或略带金属光泽的菌落;淡紫红色,中心色较深的菌落。如图3。

图3 大肠菌群在伊红美蓝培养基上的特征
③ 复发酵试验:上述涂片镜检的菌落如为革兰氏阴性无芽孢的杆菌,则挑选该菌落的另一部分接种于普通浓度乳糖蛋白胨培养液中(内有倒管),每管可接种分离自同一初发酵管(瓶)的最典型菌落1~3个,然后置于37℃恒温箱中培养24h,有产酸产气者,即证实有大肠菌群菌存在。根据证实有大肠菌群存在的阳性管(瓶)数查表1,报告每升水样中的大肠菌群数。
表1大肠菌群检数表(接种水样100 mL 2份,10 mL 10份,总量300 mL)
|
10mL水量的阳性管数 |
100mL水量的阳性瓶数 |
||
|
0 |
1 |
2 |
|
|
1L水样中大肠菌群数 |
|||
|
0 |
<3 |
4 |
11 |
|
1 |
3 |
8 |
18 |
|
2 |
7 |
13 |
27 |
|
3 |
11 |
18 |
38 |
|
4 |
14 |
24 |
52 |
|
5 |
18 |
30 |
70 |
|
6 |
22 |
36 |
92 |
|
7 |
27 |
43 |
120 |
|
8 |
31 |
51 |
161 |
|
9 |
36 |
60 |
230 |
|
10 |
40 |
69 |
>230 |
(2)水源水
① 将水样作1:10稀释。
② 于各装有5mL倍浓缩乳糖蛋白胨培养液的五个试管中(内有倒管),各加10mL水样;于各装有10mL乳糖蛋白胨培养液的五个试管中(内有倒管),各加1mL水样;于各装有10mL乳糖蛋白胨培养液的五个试管中(内有倒管),各加入1 mL1:10稀释的水样。共计15管,三个稀释度,将各管充分混匀,置于37℃恒温箱培养24h。
③ 平板分离和复发酵试验的检验步骤同(1)生活饮用水检验方法。
④ 根据证实总大肠菌群存在的阳性管数查MPN表,即求得每100mL水样中存在的总大肠菌群数。
(3)地表水和废水
① 地衣水中较清洁水的初发酵试验步骤同(2)水源水检验方法。有严重污染的地表水和废水初发酵试验的接种水样应作1:10,1:100,1:1000或更高的稀释,检验步骤同(2)水源水检验方法。
② 如果接种的水样量不是10mL,1mL和0.1mL,而是较低的或较高的三个浓度的水样量,也可查表求得MPN指数,再经下面的公式换算成每100mL的MPN值。

三、相关培养基的采购
九州登录网页中国有限公司有适用于水中大肠菌群检验的相关培养基,客户可根据实际情况和用途进行选用。
|
产品编号 |
产品名称 |
规格 |
产品说明及用途 |
|
HB0119 |
250g |
用于饮用水,水源水中总大肠菌群的测定 |
|
|
HBPT009 |
10mL*20支/盒 |
用于大肠菌群、大肠杆菌的测定 |
|
|
HB0118 |
250g |
用于饮用水和水源水中总大肠菌群的选择性分离和确证(GB标准) |
|
|
HB0107 |
250g |
弱选择性培养基,用于分离肠道致病菌,特别是大肠杆菌(GB、SN标准) |
注:本文属海博生物原创,未经允许不得转载。
上一篇:毛癣菌琼脂(5)
下一篇:没有了!
| 相关文章: | ||



